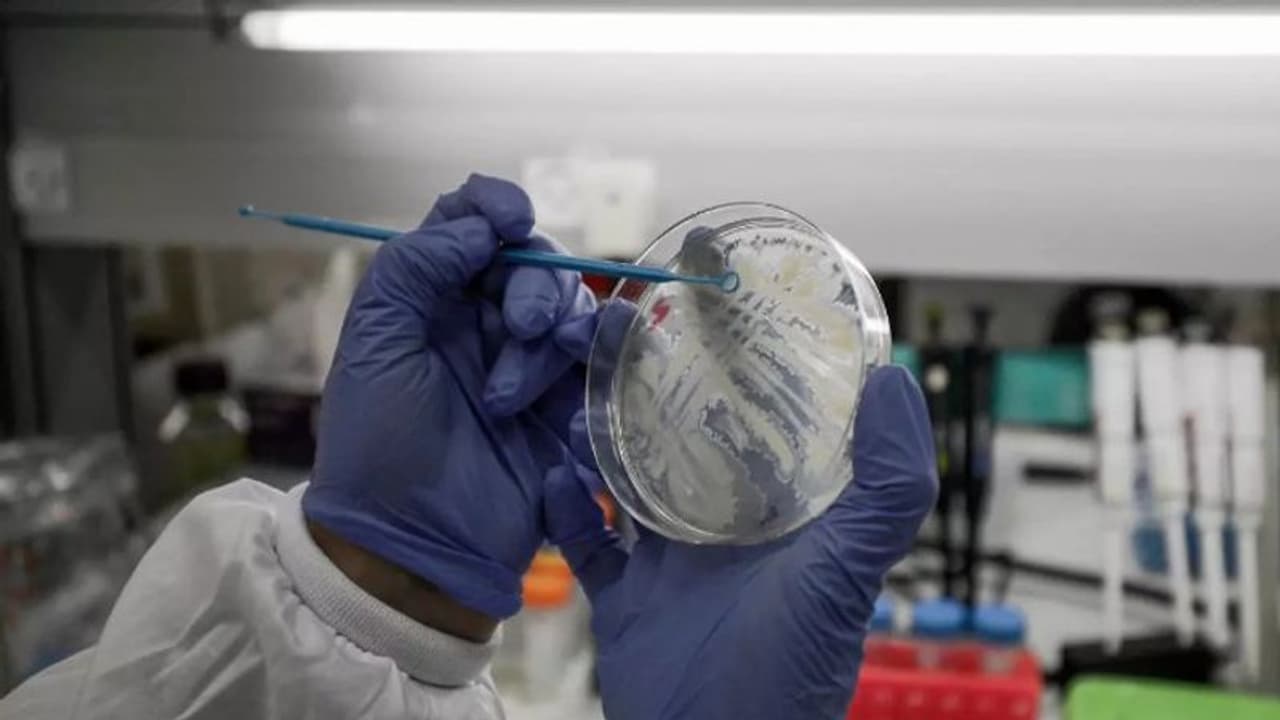
കൊവിഡ് 19; രണ്ട് വാക്സിൻ കൂടി മനുഷ്യരിൽ പരീക്ഷിക്കാൻ ചൈന

കൊവിഡ് മഹാമാരിക്കെതിരായ വാക്സിൻ ഗവേഷണത്തിലാണ് ശാസ്ത്രലോകം. ഇതു സംബന്ധിച്ച് പ്രതീക്ഷ തരുന്ന പല വാര്ത്തകളും നാം കേള്ക്കുന്നുമുണ്ട്. അക്കൂട്ടത്തില് ഏറ്റവും ഒടുവിലത്തെ വാര്ത്ത വരുന്നത് ചൈനയില് നിന്നാണ്.
ബെയ്ജിങ് കേന്ദ്രമായ സിനോവക് ബയോടെക്, വുഹാൻ ഇൻസ്റ്റിറ്റ്യൂട്ട് ഓഫ് ബയോളജിക്കൽ പ്രൊഡക്ട്സ് ആൻഡ് വുഹാൻ ഇൻസ്റ്റിറ്റ്യൂട്ട് ഓഫ് വൈറോളജി എന്നിവ വികസിപ്പിച്ചതാണു വാക്സിനുകൾ. ഞായർ, തിങ്കൾ ദിവസങ്ങളിലായി ഫൂഡ് ആൻഡ് ഡ്രഗ് അഡ്മിനിസ്ട്രേഷനാണു ക്ലിനിക്കൽ ട്രയൽസിന് അനുമതി നൽകിയതെന്നു സയൻസ് ആൻഡ് ടെക്നോളജി മന്ത്രാലയത്തിലെ ഉദ്യോഗസ്ഥൻ വു യുവാൻബിൻ വാർത്താസമ്മേളനത്തിൽ വ്യക്തമാക്കി.
മിലിറ്ററി മെഡിക്കൽ സയൻസസും ഹോങ്കോങ്ങിലെ കാൻസിനോ ബയോയും ചേർന്നു വികസിപ്പിച്ച വാക്സിന്റെ പരീക്ഷണത്തിന് മാർച്ച് 16ന് അനുമതി നൽകിയിരുന്നു. രണ്ടാംഘട്ട ട്രയല് ഈ മാസം 9ന് ആരംഭിച്ചു. രണ്ടാംഘട്ട ക്ലിനിക്കൽ ട്രയൽസ് നടപടികൾക്കു തുടക്കമിടുന്ന ലോകത്തെ ആദ്യ രാജ്യമാണ് ചൈനയെന്നു വു യുവാൻബിൻ പറഞ്ഞു. എന്നാല് 18 മാസം വരെ എടുക്കും ഒരു വാക്സിന് പൂര്ണ്ണമായി നിലവില് വരാനെന്നാണ് വിദഗ്ധര് പറയുന്നത്.
ഏഷ്യാനെറ്റ് ന്യൂസ് പ്രധാന വാർത്താ സ്രോതസായി തെരഞ്ഞെടുക്കുക